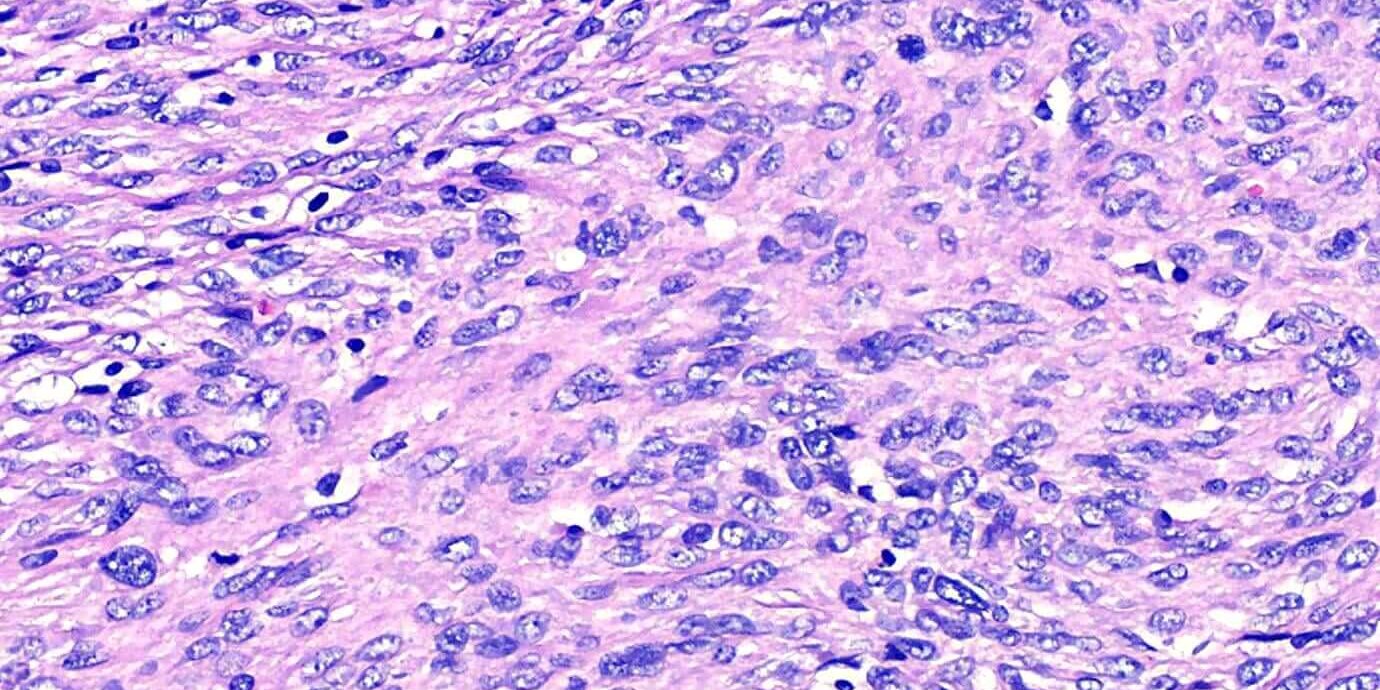

外科手術切除,是臨床醫師在處理動物腫瘤時非常常用的方法之一。切除後的組織檢體,醫師會送檢進行進行組織病理學檢查,除為了知道腫瘤類型外,另一個想確認的重點及是腫瘤邊界是否完整,以及是否發生轉移(metastasis)。
淋巴結轉移的發生與否,對動物的臨床預後(prognosis)有顯著的影響。皮膚腫瘤通常在轉移到維生臟器(如肺臟、肝臟、腎臟等處)之前,往往會先轉移到臨近的淋巴組織,臨床上就可以見到淋巴結腫大的病灶出現。在未有淋巴結轉移發生前,完整的切除皮膚腫瘤後,患病動物復發腫瘤或出現遠端轉移的機會就小很多,也就是有比較良好的臨床預後。
————————————
本病例是一個犬的皮膚腫瘤,臨床醫師在手術時一併採集了周圍的淋巴結。檢查結果發現,淋巴結嚴重被腫瘤侵犯,有大半的淋巴結組織消失。組織病理學發現這個結果,臨床就須要特別注意患病動物未來是否有內臟出現轉移的狀況,可以即早與飼主對治療計劃進行溝通。
透過這個病例,也提醒我們病理檢查的重要性,如果醫師沒有將淋巴結組織送檢,可能就無法發現腫瘤已經轉移了。手術切除的腫塊,不論經驗或細胞學檢查結果為何,所有外科檢體都應該進行病理學檢查,才能提供患病動物最準確的治療方向!
感謝 宏力24小時急診後送動物醫院
及 #馮宗宏 院長提供本病例